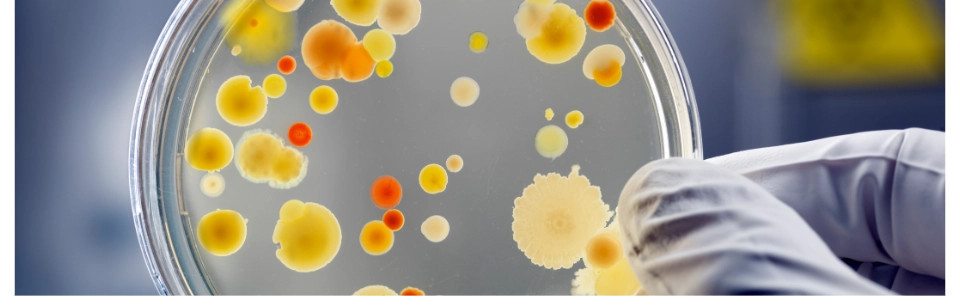
Baktérie pre náročné použitie a špeciálne projekty

Nákupný košík
Vo vašom košíku nie sú žiadne ďalšie položky
Baktérie pre náročné použitie a špeciálne projekty
Nie sú k dispozícii žiadne produkty.
Overené našimi zákazníkmi
Pozrite si vybrané hodnotenia našich zákazníkov.
Výhody:
overená kvalita, rýchle dodanie
overená kvalita, rýchle dodanie

Jarmila P. 02.02.2026





Celkový názor:
Rychle dodanie.
Rychle dodanie.

Maroš C. 08.01.2026





Výhody:
Rychle dodanie
Rychle dodanie

Vladimir G. 19.12.2025





Celkový názor:
vyhodu
vyhodu

Ondrej B. 25.11.2025





Celkový názor:
Rýchle dodanie
Rýchle dodanie

Bartolomej L. 16.11.2025





Výhody:
Rýchle vybavenie Dobrá cena tovaru Komunikácia
Celkový názor:
V obchode nakupujeme opakovane, vždy všetko prebehlo bez akýchkoľvek komplikácií. Dobrá cena, rýchle vybavenie objednávky a jej doručenie, vždy starostlivo zabalená.
Rýchle vybavenie Dobrá cena tovaru Komunikácia
Celkový názor:
V obchode nakupujeme opakovane, vždy všetko prebehlo bez akýchkoľvek komplikácií. Dobrá cena, rýchle vybavenie objednávky a jej doručenie, vždy starostlivo zabalená.

Juraj P. 13.11.2025





